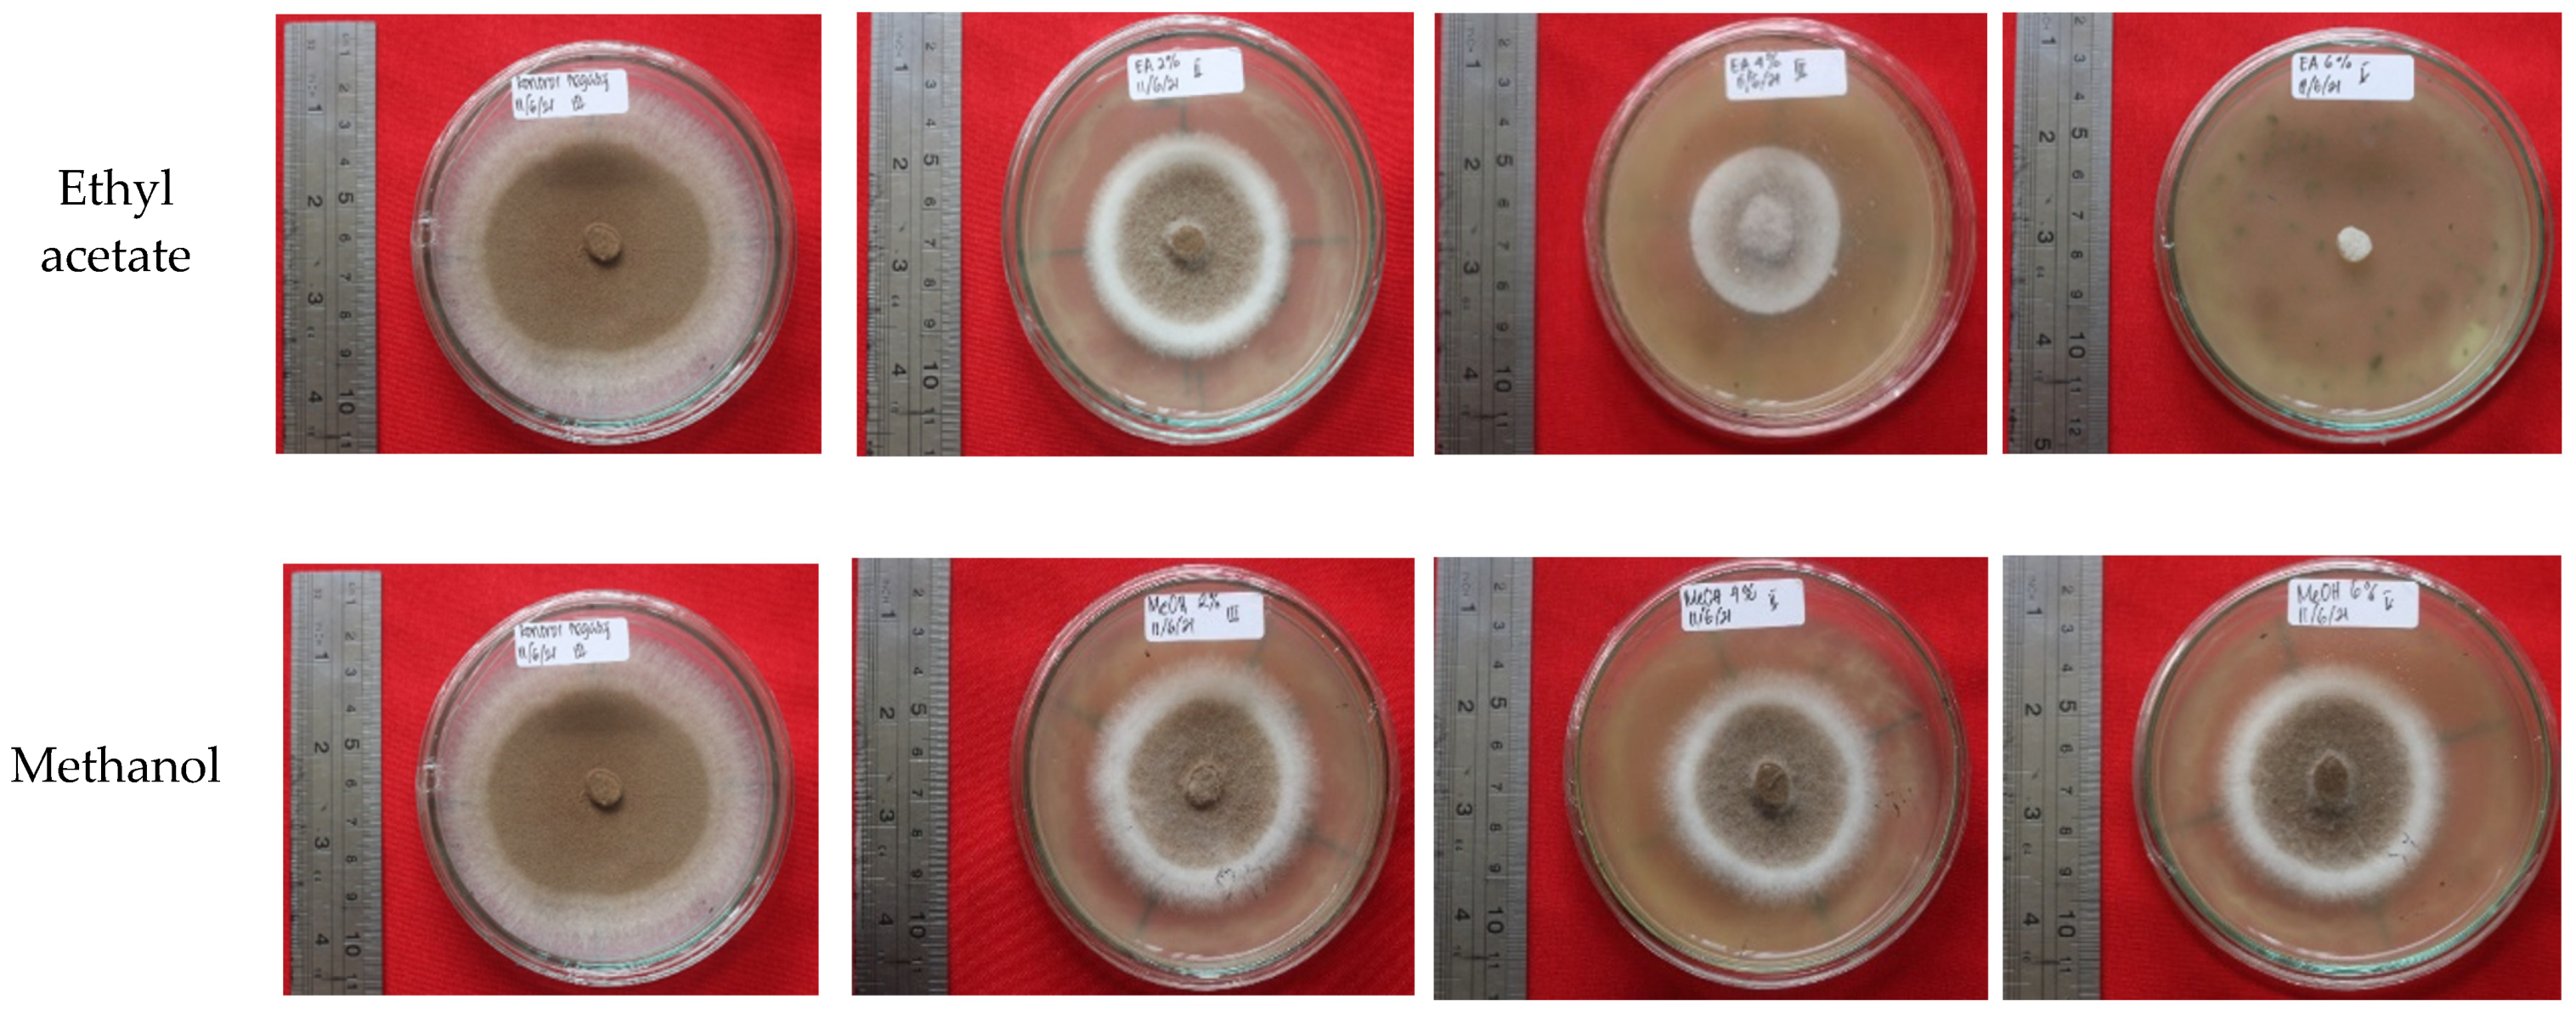
Forests 12 01591 g004a 550
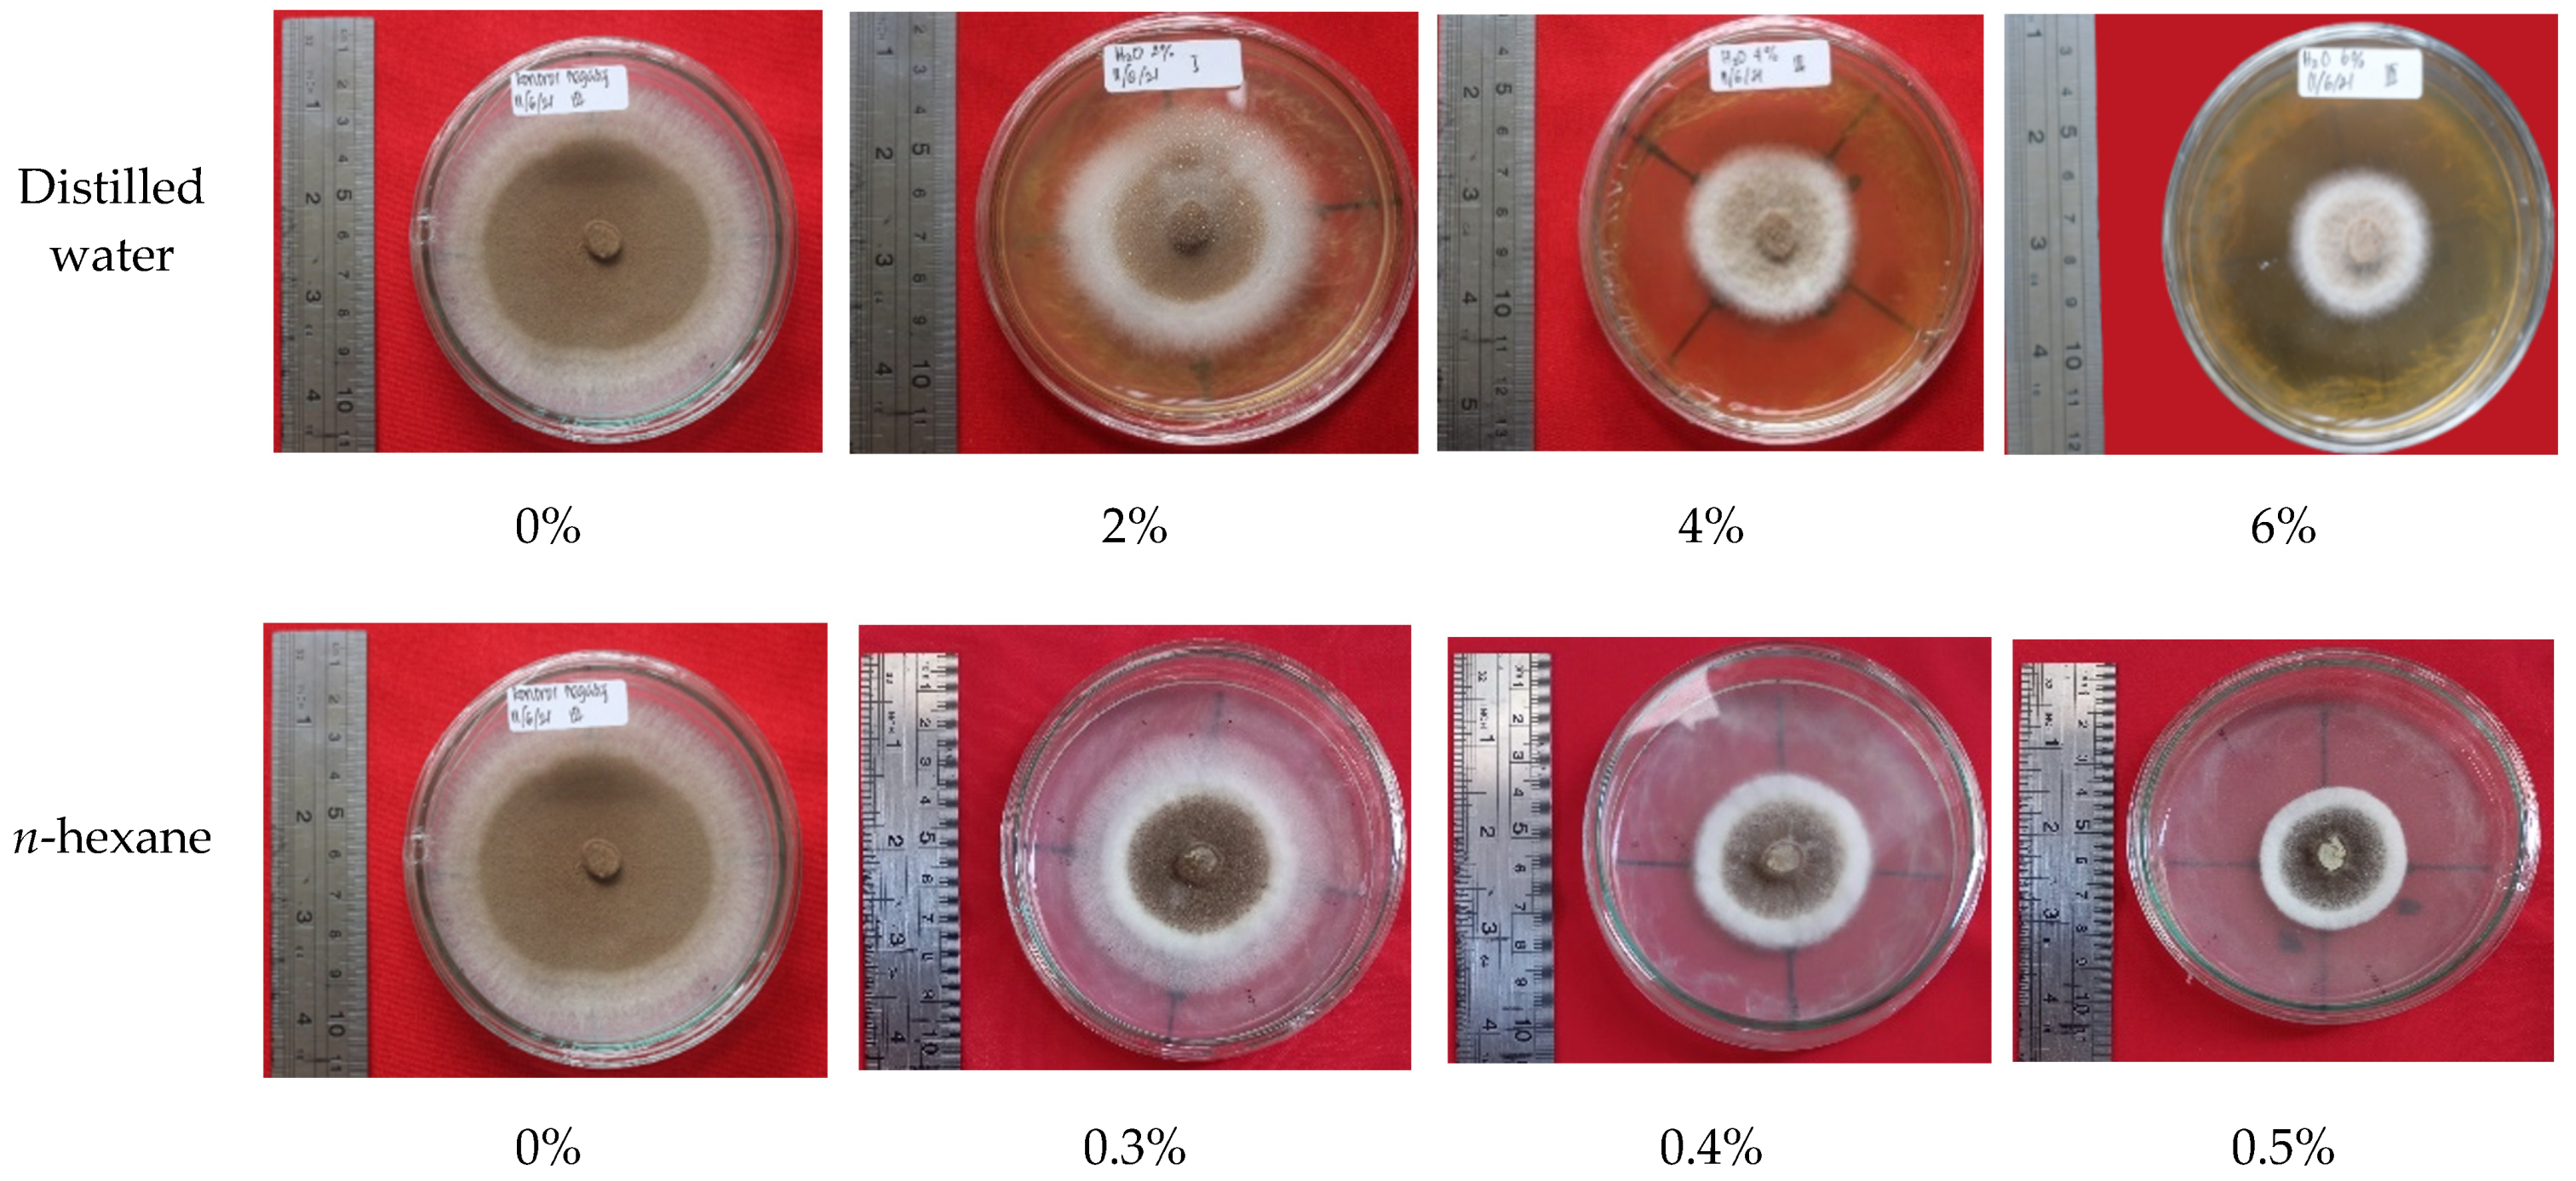
Forests 12 01591 g004b 550

Chemical Components of Fungus Comb from Indo-Malayan Termite Macrotermes gilvus Hagen Mound and Its Bioactivity against Wood-Staining Fungi
Abstract
:1. Introduction
2. Materials and Methods
2.1. Termite-Mound Survey and Fungus-Comb Collection
2.2. Termite-Species Identification
2.3. Analysis of the Chemical Content of the Fungus Combs
2.3.1. Detection of Alkaloids
2.3.2. Detection of Phenol Hydroquinone
2.3.3. Detection of Steroids and Terpenoids
2.3.4. Tannin Detection
2.3.5. Detection of Saponins
2.3.6. Solvent Extraction
2.3.7. Extract Composition
2.4. Bioactivity Test of the Fungus-Comb Extracts
2.5. Data Analysis
3. Results and Discussion
3.1. Termite Species
3.2. General Analytical Results
3.3. Secondary Metabolite Content
3.4. Amino Acids
3.5. Extractives Content
3.6. Bioactivity of Fungus-Comb Extract against Wood-Staining Fungi
4. Conclusions
Author Contributions
Funding
Institutional Review Board Statement
Informed Consent Statement
Data Availability Statement
Acknowledgments
Conflicts of Interest
References
- Krishna, K.; Grimaldi, D.A.; Krishna, V.; Engel, M.S. Treatise on the Isoptera of the World: 1 Introduction (Bulletin of the American Museum of Natural History); American Museum of Natural History: New York, NY, USA, 2013; Volume 377, p. 1. [Google Scholar]
- Nandika, D.; Rismayadi, Y.; Diba, F. Rayap: Biologi Dan Pengendaliannya [Termite: Biology and Its Control], 2nd ed.; Universitas Muhamadiyah: Surakarta, Indonesia, 2015. [Google Scholar]
- Subekti, N. Distribution Patterns, Architecture and Population Density of Subterranean Termites Macrotermes gilvus Hagen (Blattodea: Termitidae) in Yanlappa Nature Reserve, West Java. Ph.D. Thesis, Faculty of Forestry, IPB University, Bogor, Indonesia, 2010. [Google Scholar]
- Hadi, Y.S.; Massijaya, M.Y.; Arinana, A. Subterranean termite resistance of polystyrene-treatedwood from three tropicalwood species. Insects 2016, 7, 37. [Google Scholar] [CrossRef] [Green Version]
- Kusumawardhani, D.T.; Nandika, D.; Karlinasari, L.; Arinana, A.; Batubara, I. Architectural and physical properties of fungus comb from subterranean termite macrotermes gilvus (Isoptera: Termitidae) mound. Biodiversitas 2021, 22, 1627–1634. [Google Scholar] [CrossRef]
- Arinana, A.; Aldina, R.; Nandika, D.; Rauf, A.; Harahap, I.S.; Sumertajaya, I.M.; Bahtiar, E.T. Termite diversity in urban landscape, South Jakarta, Indonesia. Insects 2016, 7, 20. [Google Scholar] [CrossRef] [PubMed] [Green Version]
- Arshad, M.A.; Schnitzer, M. The chemistry of a termite fungus comb. Plant Soil 1987, 98, 247–256. [Google Scholar] [CrossRef]
- Singh, K.; Muljadi, B.P.; Raeini, A.Q.; Jost, C.; Vandeginste, V.; Blunt, M.J.; Theraulaz, G.; Degond, P. The architectural design of smart ventilation and drainage systems in termite nests. Sci. Adv. 2019, 5, 8520. [Google Scholar] [CrossRef] [PubMed] [Green Version]
- De Fine Licht, H.H.; Boomsma, J.J.; Aanen, D.K. Presumptive horizontal symbiont transmission in the fungus-growing termite Macrotermes natalensis. Mol. Ecol. 2006, 15, 3131–3138. [Google Scholar] [CrossRef]
- Schisler, L.C.; Chang, S.T.; Quimio, T.G. Tropical Mushrooms: Biological Nature and Cultivation Methods. Mycologia 2005, 76, 383. [Google Scholar] [CrossRef]
- Rouland-Lefèvre, D.; Inoue, T.; Johjima, T. Termitomyces/Termite Interactions. In Intestinal Microorganisms of Termites and Other Invertebrates; Springer: Berlin/Heidelberg, Germany, 2006; pp. 335–350. [Google Scholar]
- Qian, G.; Li, S.; Wen, H. Fungal diversity of fungus comb in termite nests. Mycosystema 2011, 30, 556–565. [Google Scholar]
- Shaleh, I.; Jannual, N.; Hasin, S.; Kaewgrajang, T.; Raffiudin, R.; Nipitwattanaphon, M. Identification of fungus-growing termites and mutualistic Termitomyces from two provinces in Thailand. Int. J. Trop. Insect Sci. 2020, 41, 1555–1566. [Google Scholar] [CrossRef]
- Batra, L.R.; Batra, S.W.T. Fungus growing termites of tropical India and associated fungi. J. Kans. Entomol. Soc. 1966, 39, 725–738. [Google Scholar]
- Thomas, R.J. Factors affecting the distribution and activity of fungi in the nests of Macrotermitinae (Isoptera). Soil Biol. Biochem. 1987, 19, 343–349. [Google Scholar] [CrossRef]
- Anwar, T.; Qureshi, H.; Mahnashi, M.H.; Kabir, F.; Parveen, N.; Ahmed, D.; Afzal, U.; Batool, S.; Awais, M.; Alyami, S.A.; et al. Bioherbicidal ability and weed management of allelopathic methyl esters from Lantana camara. Saudi J. Biol. Sci. 2021, 28, 4365–4374. [Google Scholar] [CrossRef]
- Daniel, G. Fungal Degradation of Wood Cell Walls. In Secondary Xylem Biology: Origins, Functions, and Applications; Kim, Y.S., Funada, R., Singh, A.P., Eds.; Academic Press: London, UK, 1986; pp. 139–141. [Google Scholar]
- Salman, A.B.A.; Sudirman, S.L.; Nandika, D. Selection of stain fungi on rubberwood (Hevea brasiliensis) and its growth response against chitosan. Biodiversitas 2020, 21, 4501–4508. [Google Scholar] [CrossRef]
- OldertrØen, K.; H-Kittikun, A.; Phongpaichit, S.; Riyajan, S.; Teanpaisal, R. Treatment of rubberwood (Hevea brasiliensis) (Willd. ex. a juss) Muell. Arg. with maleic anhydride to prevent moulds. J. Forensic Sci. 2016, 62, 314–321. [Google Scholar]
- George, J. Preservative treatment of bamboo, rubberwood and coconut palm—Simple methods for treating building timbers. In Preservation of Timber in the Tropics; Findlay, W.P.K., Ed.; Kluwer Academic: Norwell, MA, USA, 1985; pp. 233–248. [Google Scholar]
- Drewello, R.; Weißmann, R. Microbiology influenced corrosion of glass. Appl. Microbiol. Biotechnol. 1997, 47, 337–346. [Google Scholar] [CrossRef]
- Müller, E.; Drewello, U.; Drewello, R.; Weißmann, R.; Wuertz, S. In situ analysis of biofilms on historic window glass using confocal laser scanning microscopy. J. Cult. Herit. 2001, 2, 31–42. [Google Scholar] [CrossRef]
- Pinto, C.; Palomar, T.; Alves, L.C.; da Silva, S.H.M.; Monteiro, R.C.; Macedo, M.F.; Villarigues, M.G. Fungal biodeterioration of stained-glass windows in monuments from Belem do Para (Brazil). Int. Biodeterior. Biodegrad. 2019, 138, 106–113. [Google Scholar] [CrossRef]
- Badan Pusat Statistik. Statistik Produksi Kehutanan 2018; Badan Pusat Statistik: Jakarta, Indonesia, 2019.
- Hadi, Y.S.; Massijaya, M.Y.; Abdillah, I.B.; Pari, G.; Arsyad, W.O.M. Color change and resistance to subterranean termite attack of mangium (Acacia mangium) and sengon (Falcataria moluccana) smoked wood. J. Korean Wood Sci. Technol. 2020, 48, 1–11. [Google Scholar]
- Valiante, V.; Baldin, C.; Hortschansky, P.; Jain, R.; Thywiben, A.; Starbburger, M.; Shelest, E.; Heinekamp, T.; Brakhage, A.A. The Aspergillus fumigatus conidial melanin production is regulated by the bifunctional bHLH Devr and MADS-box RlmA transcription factor. Mol. Microbiol. 2016, 102, 321–335. [Google Scholar] [CrossRef] [Green Version]
- Muzaffer, A. Key to the Indomalayan termites. Biologia 1958, 4, 33–198. [Google Scholar]
- Tho, Y.P.; Kirton, L.G.L. Termites of Peninsular Malaysia (Malayan Forest Records No. 36); Forest Research Institute Malaysia: Kuala Lumpur, Malaysia, 1992.
- Lou, J.; Zhang, J.; Xu, S.; Wang, D.; Fan, X. New Method to Evaluate the Crosslinking Degree of Resin Finishing Agent with Cellulose Using Kjeldahl Method and Arrhenius Formula. Processes 2021, 9, 767. [Google Scholar] [CrossRef]
- Harborne, J. Metode Fitokimia Penuntun Cara Modern Menganalisa Tumbuhan. In Phytochemical Methods: A Guide to Modern Techniques of Plant Analysis (In English), 2nd ed.; Padmawinata, K., Soediro, I., Eds.; ITB: Bandung, Indonesia, 1984; pp. 47–102, 152–153. [Google Scholar]
- Liu, Y.; Benohoud, M.; Yamdeu, J.H.G.; Gong, Y.Y.; Orfila, C. Green extraction of polyphenols from citrus peel by-products and their antifungal activity against Aspergillus Flavus. Food Chem. X 2021, 12, 100144. [Google Scholar] [CrossRef] [PubMed]
- Singh, T. Migration of methylene bis thiocyanate in wood and its effect on a wood degrading fungus. Eur. J. For. Res. 2008, 127, 195–202. [Google Scholar] [CrossRef]
- Subekti, N.; Solihin, D.D.; Nandika, D.; Surjokusumo, S.; Anwar, S. Distribution and morphology characteristic of Macrotermes gilvus Hagen in the natural habitat. J. Ilmu Dan Teknol. Has. Hutan 2008, 1, 27–33. [Google Scholar]
- Otani, S.; Challinor, V.L.; Kreunzenbeck, N.B.; Kildgaard, S.; Cristensen, S.K.; Larsen, L.L.M.; Aanen, D.K.; Rasmussen, S.A.; Beemelmanns, C.; Poulsen, M. Disease-free monoculture farming by fungus-growing termites. Sci. Rep. 2019, 9, 8819. [Google Scholar]
- Grasse, P.P. Termitologia; Masson: Paris, France, 1982; Volume I. [Google Scholar]
- Johnson, R.A. Colony development and establishment of fungus comb in Microtermes sp. nr. umbaricus Sjöstedt (Isoptera, Macrotermitinae) from Nigeria. J. Nat. Hist. 1981, 32, 3–12. [Google Scholar]
- Yang, G.; Ahmad, F.; Zhou, Q.; Guo, M.; Liang, S.; Gaal, H.A.; Mo, J. Investigation of physicochemical indices and microbial communities in temite fungus-combs. Front. Microbiol. 2021, 11, 581219. [Google Scholar] [CrossRef]
- Sawhasan, P.; Worapong, J.; Flegel, T.W.; Vinijsanun, T. Fungal partnerships stimulate growth of Termitomyces clypeatus stalk mycelium in vitro. World J. Microbiol. Biotechnol. 2012, 28, 2311–2318. [Google Scholar] [CrossRef]
- Arifin, Z.; Dahlan, Z.; Irsan, C.S.; Hartono, Y. Impact of the presence of subterranean termites Macrotermes gilvus (Termitidae) to physico-chemical soil modification on the rubber plantation land. J. Ecol. Nat. Environ. 2016, 8, 13–19. [Google Scholar]
- Korb, J. Termite mound architecture, from function to construction. In Biology of Termites: A Modern Synthesis; Springer: Dordrecht, The Netherlands; Heidelberg, Germany; London, UK; New York, NY, USA, 2011; pp. 349–373. [Google Scholar]
- Chiu, C.; Ou, J.; Chen, C.; Li, H. Odontotermes formosanus regulate α-amino acid and fatty acids with their symbiont fungus. In Proceedings of the 12th Pasific Rim Termite Research Group Conference, Yogyakarta, Indonesia, 21–22 March 2018; pp. 28–33. [Google Scholar]
- De Ullivarri, M.F.; Arbulu, S.; Garcia-Gutierrez, E.; Cotter, P.D. Antifungal Peptides as Therapeutic Agents. Front. Cell. Infect. Microbiol. 2020, 17, 105. [Google Scholar] [CrossRef]
- Hoseini, S.M.; Ahmad, K.M.; Yousefi, M.; Costas, B. Roles of arginine in fish nutrition and health: Insights for future researches. Rev. Aquac. 2020, 12, 2091–2108. [Google Scholar] [CrossRef]
- Gambardella, J.; Khondkar, W.; Morelli, M.B.; Wang, X.; Santulli, G.; Trimarco, V. Arginine and endothelial function. Biomedicines 2020, 8, 277. [Google Scholar] [CrossRef] [PubMed]
- Prastya, M.E.; Astuti, R.I.; Batubara, I.; Takagi, H.; Wahyudi, A.T. Natural extract and its fractions isolated from the marine bacterium Pseudoalteromonas flavipulchra STILL-33 have antioxidant and antiaging activities in Schizosaccharomyces pombe. FEMS Yeast Res. 2020, 20, 3. [Google Scholar] [CrossRef] [PubMed]
- Zhang, L.; Li, F.; Guo, Q.; Duan, Y.; Wang, W.; Zhong, Y.; Yang, Y.; Yin, Y. Leucine supplementation: A novel strategy for modulating lipid metabolism and energy homeostasis. Nutrients 2020, 12, 1299. [Google Scholar] [CrossRef]
- Theis, N.; Brown, M.A.; Wood, P.; Waldron, M. Leucine Supplementation Increases Muscle Strength and Volume, Reduces Inflammation, and Affects Wellbeing in Adults and Adolescents with Cerebral Palsy. J. Nutr. 2021, 151, 59–64. [Google Scholar] [CrossRef] [PubMed]
- Fierens, T.; Servaes, K.; Van Holderbeke, M.; Geerts, L.; De Henauw, S.; Sioen, I.; Vanermen, G. Analysis of phthalates in food products and packaging materials sold on the Belgian market. Food Chem. Toxicol. 2012, 50, 2575–2583. [Google Scholar] [CrossRef]
- Ortiz, A.; Sansinenea, E. Di-2-ethylhexylphthalate May Be a Natural Product, Rather than a Pollutant. J. Chem. 2018, 2018, 6040814. [Google Scholar] [CrossRef]
- Ma, T.T.; Luo, Y.M.C.; Teng, Y. Phthalate esters contamination in soil and plants on agricultural land near an electronic waste recycling site. Environ. Geochem. Health 2013, 35, 465–476. [Google Scholar] [CrossRef] [PubMed]
- El-Sayed, M.H. Di-(2-ethylhexyl) phthalate, a major bioactive metabolite with antimicrobial and cytotoxic activity isolated from the culture filtrate of newly isolated soil streptomyces (Streptomyces mirabilis) Strain NSQu-25. World Appl. Sci. J. 2012, 20, 1202–1212. [Google Scholar]
- Qi, S.H.; Xu, Y.; Xiong, H.R.; Qian, P.Y.; Zhang, S. Antifouling and antibacterial compounds from a marine fungus Cladosporium sp. F14. World J. Microbiol. Biotechnol. 2009, 25, 399–406. [Google Scholar] [CrossRef]
- Xiong, H.; Qi, S.; Xu, Y.; Miao, L.; Qian, P.Y. Antibiotic and antifouling compound production by the marine-derived fungus Cladosporium sp. F14. J. Hydro-Environ. Res. 2009, 24, 264–270. [Google Scholar] [CrossRef]
- Lu, G.; Liu, T.; Wang, N.; Dou, Z.; Wang, K.; Zuo, Y. Nematicidal Effect of Methyl Palmitate and Methyl Stearate against Meloidogyne incognita in Bananas. J. Agric. Food Chem. 2020, 68, 6502–6510. [Google Scholar] [CrossRef] [PubMed]
- Bashir, A. Chemical composition and antifungal, phytotoxic, brine shrimp cytotoxicity, insecticidal and antibacterial activities of the essential oils of Acacia modesta. J. Med. Plants Res. 2012, 6, 31. [Google Scholar]
- Ohe, V.R.; Aalizadeh, R.; Schymanski, S. S13|EUCOSMETICS|Combined Inventory of Ingredients Employed in Cosmetic Products (2000) and Revised Inventory (2006). 2021. Available online: https://doi.org/10.5281/zenodo.3821156 (accessed on 25 August 2021).
- Mota, C.J.A.; Pinto, B.P.; de Lima, A.L. Glycerol: A Versatile Renewable Feedstock for the Chemical Industry; Springer International: Zurich, Switzerland, 2017; pp. 10–11. [Google Scholar]
- Lebwohl, M.G.; Heymann, H.Y.; Berth-Jones, J.; Coulson, I. Treatment of Skin Disease: Comprehensive Therapeutic Strategies, 5th ed.; Elsevier: Amsterdam, The Netherlands, 2017. [Google Scholar]
- Velmurugan, N.; Han, S.S.; Lee, Y.S. Antifungal activity of neutralized wood vinegar with water extracts of Pinus densiflora and Quercus serrata saw dusts. Int. J. Environ. Resour. 2009, 3, 167–176. [Google Scholar]
- Oramahi, H.A.; Diba, F.; Wahdina. Antifungal activity of liquid smoke from sawdust of acacia wood (Acacia mangium Willd) and laban wood (Vitex pubescens Vahl). J. Ilmu-Ilmu Hayati Dan Fis. 2011, 13, 79–84. [Google Scholar]
- Sitepu, I.; Suada, I.; Susrama, I. The Antimicrobial Activity Test of Some Kitchen Seasoning Extracts on Growth of Fungus Curvularia lunata (Wakk.) Boed. and Aspergillus flavus Link. E-J. Agroekoteknologi Trop. 2012, 1, 2. [Google Scholar]
- Kelland, M.A. Production Chemicals for the Oil and Gas Industry; CRC Press: Boca Raton, FL, USA, 2014. [Google Scholar]
- Balouiri, M.; Sadiki, M.; Ibnsouda, S.K. Methods for in vitro evaluating antimicrobial activity: A review. J. Pharm. Anal. 2016, 6, 71–79. [Google Scholar] [CrossRef] [Green Version]
- Padmini, E.; Valarmathi, A.; Rani, M. Comparative analysis of chemical composition and antibacterial activities of Mentha spicata and Camellia sinensis. Asian J. Exp. Biol. Sci. 2010, 1, 772–778. [Google Scholar]
- Nazarudin, M.F.; Isha, A.; Mastuki, S.N.; Ain, N.M.; Ikhsan, N.F.M.; Abidin, A.Z.; Aliyu-Paiko, M. Chemical Composition and Evaluation of the α-Glucosidase Inhibitory and Cytotoxic Properties of Marine Algae Ulva intestinalis, Halimeda macroloba, and Sargassum ilicifolium. Evid Based Complement. Altern. Med. 2020, 2020, 2753945. [Google Scholar] [CrossRef]
- Rawal, J.R.; Sonawani, P.R. Determination of bioactive components of Cynodon dactylon by GC-MS analysis & it’s in vitro antimicrobial activity. Int. J. Pharm. Life Sci. 2016, 7, 4880–4885. [Google Scholar]
- Suzuki, K.; Nakano, N.; Tanaka, R.; Uyeda, M.; Shibata, M. Cell aggregation factor produced by streptomyces sp. Strain No. A-3315. Agric. Biol. Chem. 1988, 52, 2589–2595. [Google Scholar]
- Ester, A.; Mukarlina, R. Aktivitas ekstrak metanol daun sembung rambat (Mikania micrantha Kunth) terhadap pertumbuhan Phytophthora sp. Im5 dari batang jeruk siam (Citrus nobilis var. microcarpa). J. Protobiont. 2017, 6, 63–67. [Google Scholar]
- Cowan, M.M. Plant products as antimicrobial agents. Clin. Microbiol. Rev. 1999, 12, 564–582. [Google Scholar] [CrossRef] [PubMed] [Green Version]

| Parameters | % of Dry Substance | Method |
|---|---|---|
| Moisture (%) | 25.94 | Gravimetric |
| Crude protein (%) | 5.80 | HPLC |
| Crude fat (%) | 0.73 | Gravimetric |
| Acid insoluble ash (%) | 3.45 | Gravimetric |
| Crude ash (%) | 30.57 | Gravimetric |
| Crude fiber (%) | 25.46 | Gravimetric |
| Carbohydrate as starch (%) | 7.76 | Luff School |
| Total | 99.71 |
| No | Amino Acid | Content (% w/w DB) |
|---|---|---|
| 1 | Aspartic acid | 0.30 |
| 2 | Threonine | 0.18 |
| 3 | Serine | 0.17 |
| 4 | Glutamate | 0.38 |
| 5 | Proline | 0.16 |
| 6 | Glysine | 0.18 |
| 7 | Alanine | 0.18 |
| 8 | Cystine | 0.02 |
| 9 | Valine | 0.22 |
| 10 | Methionine | 0.11 |
| 11 | Ileusine | 0.27 |
| 12 | Leusine | 0.55 |
| 13 | Tyrosine | 0.01 |
| 14 | Phenylalanine | 0.24 |
| 15 | Histidine | 0.24 |
| 16 | Lysine | 0.21 |
| 17 | Arginine | 1.33 |
| Total | 4.75 | |
| Solvents | Extraction Yield (%) * |
|---|---|
| n-hexane | 0.09 |
| Ethyl acetate | 1.73 |
| Methanol | 2.53 |
| Distilled water | 4.61 |
| Compound Name | CAS No. | Relative Content (%) | Bioactivity Reported |
|---|---|---|---|
| Methyl palmitate | 112-39-0 | 4.55 | Nematicidal [54], herbicidal [16] |
| Benzenepropanoic acid, 3,5-bis(1,1 dimethylethyl)-4-hydroxy-,methyl ester | 6386-38-5 | 1.16 | Antifungi and antioxidant [55] |
| Methyl linolelaidate | 2566-97-4 | 2.03 | Emollient; Skin conditioning [56] |
| Methyl oleate | 112-62-9 | 4.17 | Emollient; Skin conditioning [56] |
| Bis(2-ethylhexyl) phthalate | 117-81-7 | 69.43 | Antibacterial [52,53] |
| Compound Name | CAS No. | Relative Content (%) | Bioactivity Reported |
|---|---|---|---|
| Glycerol | 56-81-5 | 28.93 | Humectant [58] |
| Phenol, 2-methoxy- | 90-05-1 | 8.54 | Antifungi [59] |
| Phenol, 2,6-dimethoxy- | 91-10-1 | 6.55 | Antifungi [59] |
| Bis(2-ethylhexyl) phthalate | 117-81-7 | 4.82 | Antibacterial [53,57] |
| No | Sample Name | MIC | |
|---|---|---|---|
| (%) | (mg/L) | ||
| 1. | n-hexane extract | >0.5 | >5000 |
| 2. | Ethyl-acetate extract | 6.0 | 60,000 |
| 3. | Methanol extract | >6.0 | >60,000 |
| 4. | Distilled water extract | >6.0 | >60,000 |
| 5. | MBT (positive control) | 0.5 | 5000 |
Publisher’s Note: MDPI stays neutral with regard to jurisdictional claims in published maps and institutional affiliations. |
© 2021 by the authors. Licensee MDPI, Basel, Switzerland. This article is an open access article distributed under the terms and conditions of the Creative Commons Attribution (CC BY) license (https://creativecommons.org/licenses/by/4.0/).
Share and Cite
Nandika, D.; Karlinasari, L.; Arinana, A.; Batubara, I.; Sitanggang, P.S.; Santoso, D.; Witasari, L.D.; Rachmayanti, Y.; Firmansyah, D.; Sudiana, I.K.; et al. Chemical Components of Fungus Comb from Indo-Malayan Termite Macrotermes gilvus Hagen Mound and Its Bioactivity against Wood-Staining Fungi. Forests 2021, 12, 1591. https://doi.org/10.3390/f12111591
Nandika D, Karlinasari L, Arinana A, Batubara I, Sitanggang PS, Santoso D, Witasari LD, Rachmayanti Y, Firmansyah D, Sudiana IK, et al. Chemical Components of Fungus Comb from Indo-Malayan Termite Macrotermes gilvus Hagen Mound and Its Bioactivity against Wood-Staining Fungi. Forests. 2021; 12(11):1591. https://doi.org/10.3390/f12111591
Chicago/Turabian StyleNandika, Dodi, Lina Karlinasari, Arinana Arinana, Irmanida Batubara, Putri Sari Sitanggang, Djoko Santoso, Lucia Dhiantika Witasari, Yanti Rachmayanti, Dikhi Firmansyah, I Ketut Sudiana, and et al. 2021. "Chemical Components of Fungus Comb from Indo-Malayan Termite Macrotermes gilvus Hagen Mound and Its Bioactivity against Wood-Staining Fungi" Forests 12, no. 11: 1591. https://doi.org/10.3390/f12111591
APA StyleNandika, D., Karlinasari, L., Arinana, A., Batubara, I., Sitanggang, P. S., Santoso, D., Witasari, L. D., Rachmayanti, Y., Firmansyah, D., Sudiana, I. K., & Hertanto, D. M. (2021). Chemical Components of Fungus Comb from Indo-Malayan Termite Macrotermes gilvus Hagen Mound and Its Bioactivity against Wood-Staining Fungi. Forests, 12(11), 1591. https://doi.org/10.3390/f12111591

